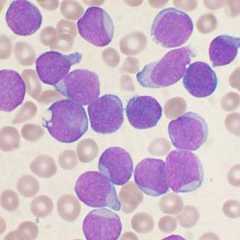
Dans la moelle osseuse d'un patient atteint de LAL, les lymphoblastes (ici précurseurs de lymphocytes&nbsp;B) sont anormalement nombreux. © VashiDonsk, Wikipedia, CC by sa 3.0

Cancer
Les derniers articlesCancer








































Peut-on utiliser une crème solaire périmée ?







Soleil : quels sont ses effets sur notre peau ?




Toucher rectal

Tabagisme passif

Sulforaphane

Parabens


Neuroblastome

Mélanome

Mastectomie

Hormonothérapie

Gynécomastie

Gynécologie

Ganglion

Galactorrhée

Euthanasie

Embolie pulmonaire

Dioxine

Cystoscopie


Chimiothérapie

Carcinome spinocellulaire
Carcinome basocellulaire

Cancer lobulaire

Cancer in situ

Cancer hématopoïétique

Cancer canalaire

Apoptose

Anticancéreux

Anti-VEGF

Anti-HER
Anti-EGFR


Leucémie aiguë lymphoblastique

Proto-oncogène

Photothérapie dynamique

Oncologie

Leucémie aiguë myéloblastique

Ipilimumab

Cancer du poumon

Cancer du pancréas

Cancer de l'ovaire

Cancer des os
Cancer de l'estomac
Cancer de l'oesophage
Cancer de la gorge
Cancer de la peau
Cancer de la prostate
Cancer de la thyroïde
Cancer de la vessie
Cancer des os
Cancer des ovaires
Cancer des testicules
Cancer du cerveau
Cancer du col de l'utérus
Cancer du colon
Cancer du foie
Cancer du pancréas
Cancer du poumon
Cancer du rein
Cancer du sang
Cancer du sein

Explorez le monde depuis chez vous !
Une fois par jour, recevez toutes nos dernières actualités.
Rejoignez nos 3,5 millions de fans sur vos réseaux sociaux favoris :
Exploration approfondie du cancer : à la pointe de la recherche médicale
Notre rubrique dédiée au cancer vous offre une série de contenus captivants sur les avancées scientifiques en matière de lutte contre le cancer. Compréhension du cancer : découvrez les mécanismes cellulaires, les facteurs de risque et les avancées en matière de prévention. Des articles informatifs élucident les aspects complexes de la maladie.
Innovations thérapeutiques : explorez les traitements novateurs et les essais cliniques révolutionnaires qui redéfinissent les normes de soins. De l'immunothérapie aux thérapies ciblées, nos contenus dressent la perspective d'avenir des traitements contre le cancer.
Actualités en temps réel : restez informé, restez engagé
Restez à jour avec nos actualités oncologiques qui couvrent les découvertes récentes, les progrès de la recherche et les initiatives mondiales dans la lutte contre le cancer. Des interviews exclusives avec des experts et des rapports détaillés vous tiennent informé des développements les plus récents.
Naviguez à travers nos articles pour accéder à une mine d'informations, des conseils de prévention aux dernières percées médicales. Futura s'engage à fournir des ressources complètes pour ceux qui cherchent à comprendre, prévenir et combattre le cancer.
Explorez les articles les plus populaires
[8]ページ先頭